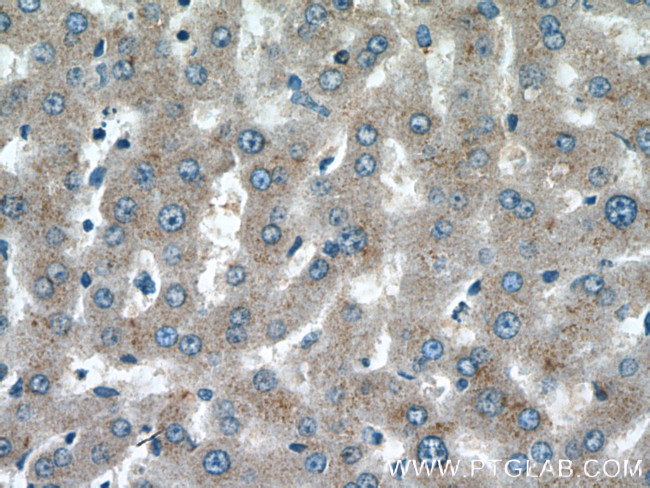
ABCG5 Antibody in Immunohistochemistry (Paraffin) (IHC (P))

Search
Proteintech
ABCG5 Polyclonal Antibody
{{$productOrderCtrl.translations['antibody.pdp.commerceCard.promotion.promotions']}}
{{$productOrderCtrl.translations['antibody.pdp.commerceCard.promotion.viewpromo']}}
{{$productOrderCtrl.translations['antibody.pdp.commerceCard.promotion.promocode']}}: {{promo.promoCode}} {{promo.promoTitle}} {{promo.promoDescription}}. {{$productOrderCtrl.translations['antibody.pdp.commerceCard.promotion.learnmore']}}
产品信息
27722-1-AP
种属反应
已发表种属
宿主/亚型
分类
类型
抗原
偶联物
形式
浓度
规格
纯化类型
保存液
内含物
保存条件
运输条件
产品详细信息
Immunogen sequence: MGDLSSLTP GGSMGLQVNR GSQSSLEGAP ATAPEPHSLG ILHASYSVSH RVRPWWDITS CRQQWTRQIL KDVSLYVESG QIMCIL (1-85 aa encoded by NM _022436)
靶标信息
The protein encoded by this gene is a member of the superfamily of ATP-binding cassette (ABC) transporters. ABC proteins transport various molecules across extra- and intra-cellular membranes. ABC genes are divided into seven distinct subfamilies (ABC1, MDR/TAP, MRP, ALD, OABP, GCN20, White). This protein is a member of the White subfamily. The protein encoded by this gene functions as a half-transporter to limit intestinal absorption and promote biliary excretion of sterols. It is expressed in a tissue-specific manner in the liver, colon, and intestine. This gene is tandemly arrayed on chromosome 2, in a head-to-head orientation with family member ABCG8. Mutations in this gene may contribute to sterol accumulation and atherosclerosis, and have been observed in patients with sitosterolemia.
仅用于科研。不用于诊断过程。未经明确授权不得转售。
生物信息学
蛋白别名: ABCG5; ATP-binding cassette sub-family G (WHITE) member 5 (sterolin 1); ATP-binding cassette sub-family G member 5; ATP-binding cassette, sub-family G (WHITE), member 5; ATP-binding cassette, sub-family G (WHITE), member 5 (sterolin 1); ATP-binding cassette, subfamily G, member 5; sterolin 1; Sterolin-1
基因别名: ABCG5; AW112016; cmp; sterolin-1; STSL; STSL2; trac
UniProt ID: (Human) Q9H222, (Rat) Q99PE7, (Mouse) Q99PE8
Entrez Gene ID: (Human) 64240, (Rat) 114628, (Mouse) 27409